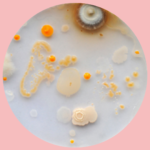
BioArt Quick &<br> (not) Dirty

◬⊡⊙ Freie Kunst Lehramt Kunst Medienkunst/Mediengestaltung Produktdesign Visuelle Kommunikation
Medienkunst/Mediengestaltung
Es geht um Informationen. Um mediale Informationen. Wie kann man sie verbreiten, wie kann man sie verarbeiten? Wie kann man Zukunft und Fiktionen denken und umsetzen? Oder Medienereignisse selbst kreieren, über die andere diskutieren? Oder neue Öffentlichkeiten entwickeln, kommunikative Räume, für zwischenmenschliche Beziehungen die Schnittstellen entwerfen? Sie sollen auch dabei helfen, die Objekte der Zukunft zu designen. Sie können auch gern die Medienkunst revolutionieren. Und, so ganz nebenbei: das Fernsehen und Radio noch dazu. Wissenschaft, Technik und Kunst schließen einander dabei nicht aus. Sie gehören unbedingt zusammen. Das hat Tradition in Weimar.
Konkret: Es erwarten Sie kleine Gruppen und individuelle Projekte, praktische Übungen und ungewöhnliche Arbeitsweisen – künstlerisch, technisch und organisatorisch. Nah am medialen Alltag.
Das Auditive und das Visuelle, das Ereignishafte, das Konzeptuelle, das Interaktive: Die Bereiche greifen ineinander, die Kombinationsmöglichkeiten sind vielfältig. Das ist das einzigartige Profil. Das ist die Medienkunst/Mediengestaltung der Bauhaus-Universität Weimar.